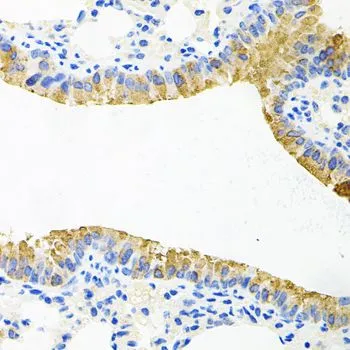

WB analysis of various sample lysates using GTX65957 TOB2 antibody. The signal was developed with ECL plus-Enhanced. Dilution : 1:1000 Loading : 25μg per lane
TOB2 antibody
GTX65957
ApplicationsWestern Blot, ImmunoHistoChemistry, ImmunoHistoChemistry Paraffin
Product group Antibodies
ReactivityHuman, Mouse, Rat
TargetTOB2
Overview
- SupplierGeneTex
- Product NameTOB2 antibody
- Delivery Days Customer9
- Application Supplier NoteWB: 1:500 - 1:2000. IHC-P: 1:100 - 1:200. *Optimal dilutions/concentrations should be determined by the researcher.Not tested in other applications.
- ApplicationsWestern Blot, ImmunoHistoChemistry, ImmunoHistoChemistry Paraffin
- CertificationResearch Use Only
- ClonalityPolyclonal
- ConjugateUnconjugated
- Gene ID10766
- Target nameTOB2
- Target descriptiontransducer of ERBB2, 2
- Target synonymsAPRO5, TOB4, TOBL, TROB2, protein Tob2, protein Tob4, transducer of erbB-2 2
- HostRabbit
- IsotypeIgG
- Protein IDQ14106
- Protein NameProtein Tob2
- Scientific DescriptionTOB2 belongs to the TOB (see TOB1; MIM 605523)/BTG1 (MIM 109580) family of antiproliferative proteins, which are involved in the regulation of cell cycle progression.[supplied by OMIM, Apr 2004]
- ReactivityHuman, Mouse, Rat
- Storage Instruction-20°C or -80°C,2°C to 8°C
- UNSPSC12352203